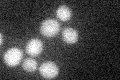
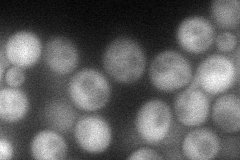

View description
Protein required, with Elongator complex, Kti11p, and Kti12p, for modification of wobble nucleosides in tRNA; has a potential role in regulatory interactions between microtubules and the cell cycle
Localization:
Intensity:
Fold change:
Significance:
-
C’ GFP library in SD
below threshold18.14 -
N' NOP1pr-GFP in SD
cytosol62.2428 -
N' TEF2pr-mCherry in SD

cytosol0 -
N' NATIVEpr-GFP in SD

below threshold24.3263 -
N' TEF2pr-VC and Cyto-VN in SD

cytosol42.3651 -
C’ GFP library in SD+DTT

cytosol18.961.04No -
C’ GFP library in SD+H2O2

cytosol19.921.09No -
C’ GFP library in Starvation Media

cytosol19.41.06No -
C’ GFP library on the background of Pup2-DaMP

below threshold -
C’ GFP library on the background of CCT mutant

below threshold21.55751.18746No
